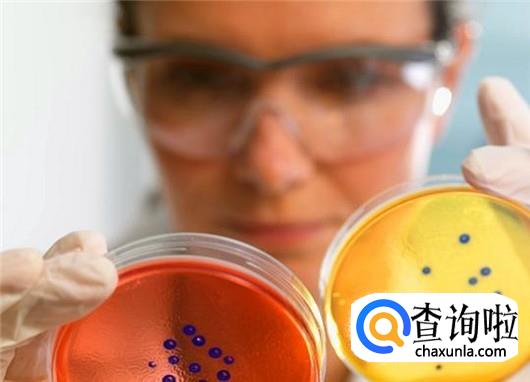

女性卖卵有什么危害?女孩子如何远离卖卵风潮?
简要回答
卖卵,这样一个叫人乍听起来摸不着头脑的词汇,近些年却在一些年轻女孩子身上不断上演,尤其是一些长相漂亮出众年轻貌美的女大学生,更是卖卵的“优选户”,不知道大家记不记得在去年三月份那个卖卵的女大学生小雨吗?一次性卖了二十颗卵子,换了两万五千块钱,然后用这些钱买了时尚手机和化妆品。别以为卖卵就像是剪几缕头发那么简单,一根又尖又长的取卵针直接刺穿阴道壁然后刺穿卵巢,在女性的卵巢里取卵,这种行为对身体的伤害几乎是一辈子的,有的女生会因为卖卵而一辈子无法生育,有的女生可能会直接丧失性命。来吧各位女孩子们,告诉你卖卵的哪些危害,并告诉你该如何远离卖卵换钱的风潮,赶紧看过来吧!
卖卵种种危害:
详细内容
- 01
卵巢重度糜烂
去年十月份,一个只有十七岁的女孩子阿丽前去卖卵,“医生”一次性取了二十一颗卵子,没几天这名十七岁的少女阿丽在一家小诊所昏迷,被送进医院后才知,因为卖卵,阿丽的双侧卵巢已经破裂,幸亏治疗及时,才将她从死亡线上拉回来,但却给卵巢留下了一辈子的伤害,卵巢重度糜烂,而子宫也做了全切除手术。
- 02
卵巢过度刺激综合征
可能很多人不知道这个卵巢过度刺激综合征到底是一种什么疾病,那么我给大家详细说一说卵巢过度刺激综合征的具体症状表现你就明白了。患上卵巢过度刺激综合征之后,卵巢快速肿胀甚至彭大好几倍,腹腔以及胸腔都会出现严重积水,分分钟都会要了一个人的命。
- 03
卵巢早衰
对于女性来说,卵巢代表着什么?妈妈,年轻,健康。而卖卵的话,这些极有可能会瞬间消失,比如说卖卵造成的卵巢早衰。不要觉得卵巢早衰的症状可能会在中年以后出现,就算是花季少女,也会因为卖卵而造成卵巢早衰症,别说做妈妈了,你连应该有的健康和青春都没了。
- 04
直接破坏处女膜
虽然这个年代有些男生对于女生是否有处女膜要求的并不是很高,可身为女孩子一定要有应该有的矜持。好好的一个女孩子就因为卖卵而让自己的处女膜瞬间消失,这是一种一辈子都无法说出口的遗憾,更会直接影响后来的感情生活。更可怕的是,取卵之后,在女性的身体上,会留下一辈子都去不掉的疤痕,一旦恋爱、结婚,这可能是导致夫妻感情适合甚至离婚的一个重要原因,毕竟没有一个男人会在乎一个没结婚就在身体上留下那么多乱七八糟疤痕的女人。
- 05
不孕
一个女人如果没有孩子,这辈子都是不完整的,虽然很多去卖卵的女孩子说,自己感觉就是疼一些,但过些日子就好了,和正常人没有什么区别,可是你的身体结构已经发生很大变化了,取卵的时候需要用一根又长又尖的取卵针刺穿阴道壁,然后直接刺穿卵巢把卵子一个个吸出来,这个过程是很可怕的,因为卵巢附近都是女性的重要器官,包括子宫肠管以及膀胱和一些血管之类,一旦出现一点点问题,会直接引发大出血而亡,轻者也会导致不孕的出现。
- 06
切莫贪钱
那些卖卵的女大学生们的最终目的,其实就是为了钱。并不是换钱给弟弟妹妹交学费,也不是给重病的亲戚交医药费,大多数都是用来自己消费,买手机,买化妆品,买首饰等等,在这样为了钱不顾一切的心态支配下,一定会奋不顾身选择卖卵的。所以说,想要原来卖卵风潮,千万不要过度贪钱,健康与生命没了,卖卵换来的一两万块钱能帮你买回什么?
- 07
不听信同学煽风点火
咱们提到的那个十七岁卖卵女孩子,本身是一名职高的学生,在同学一次次的吹嘘与鼓动下,觉得打几次针就能够换很多钱非常划算,于是冒险卖卵,这一次差点把自己的命搭上。女孩子年纪还比较小,对于社会上的一些事情还是一种迷茫状态,说白了就是过于轻信他人的话。所以说,一定不要听信同学或者其他人的卖卵鼓动。
- 08
拥有最起码的羞耻心
一般卖卵的都是非常年轻的女孩子,大都数二十岁左右的花季少女,这个年纪的女孩子一定要拥有做女孩子最起码的羞耻心。卖卵不是直接打个针就可以的,要通过女性私处进行手术的,如果是因为疾病,那也是没办法的事情,但在你清醒的情况下,进行各种检查与手术,只要有些许的羞耻心,就不会接受这样的行为。所以说,拥有一个女孩子最起码的羞耻心,你也能够在卖卵的时候“知途迷返”。
- 09
切莫抱着侥幸心理
面对卖卵换钱的女大学生,很多人不知道这些女孩子这么多年的书都读到哪儿去了,难道真的不知道卖卵的危害?难道真的拿自己的健康不当回事?不是的,身为女大学生若是不知道这些知识,真不知道这个大学是怎么考取的,只不过是抱着一种侥幸心理罢了,觉得很多人都没问题,肯定自己也没问题,在这样的侥幸心理下,就会挺然走险了。
点击排行
- 2 排行
- 3 排行
- 4 排行
- 5 排行
- 6 排行
- 7 排行
- 8 排行
- 9 排行
- 10 排行





















